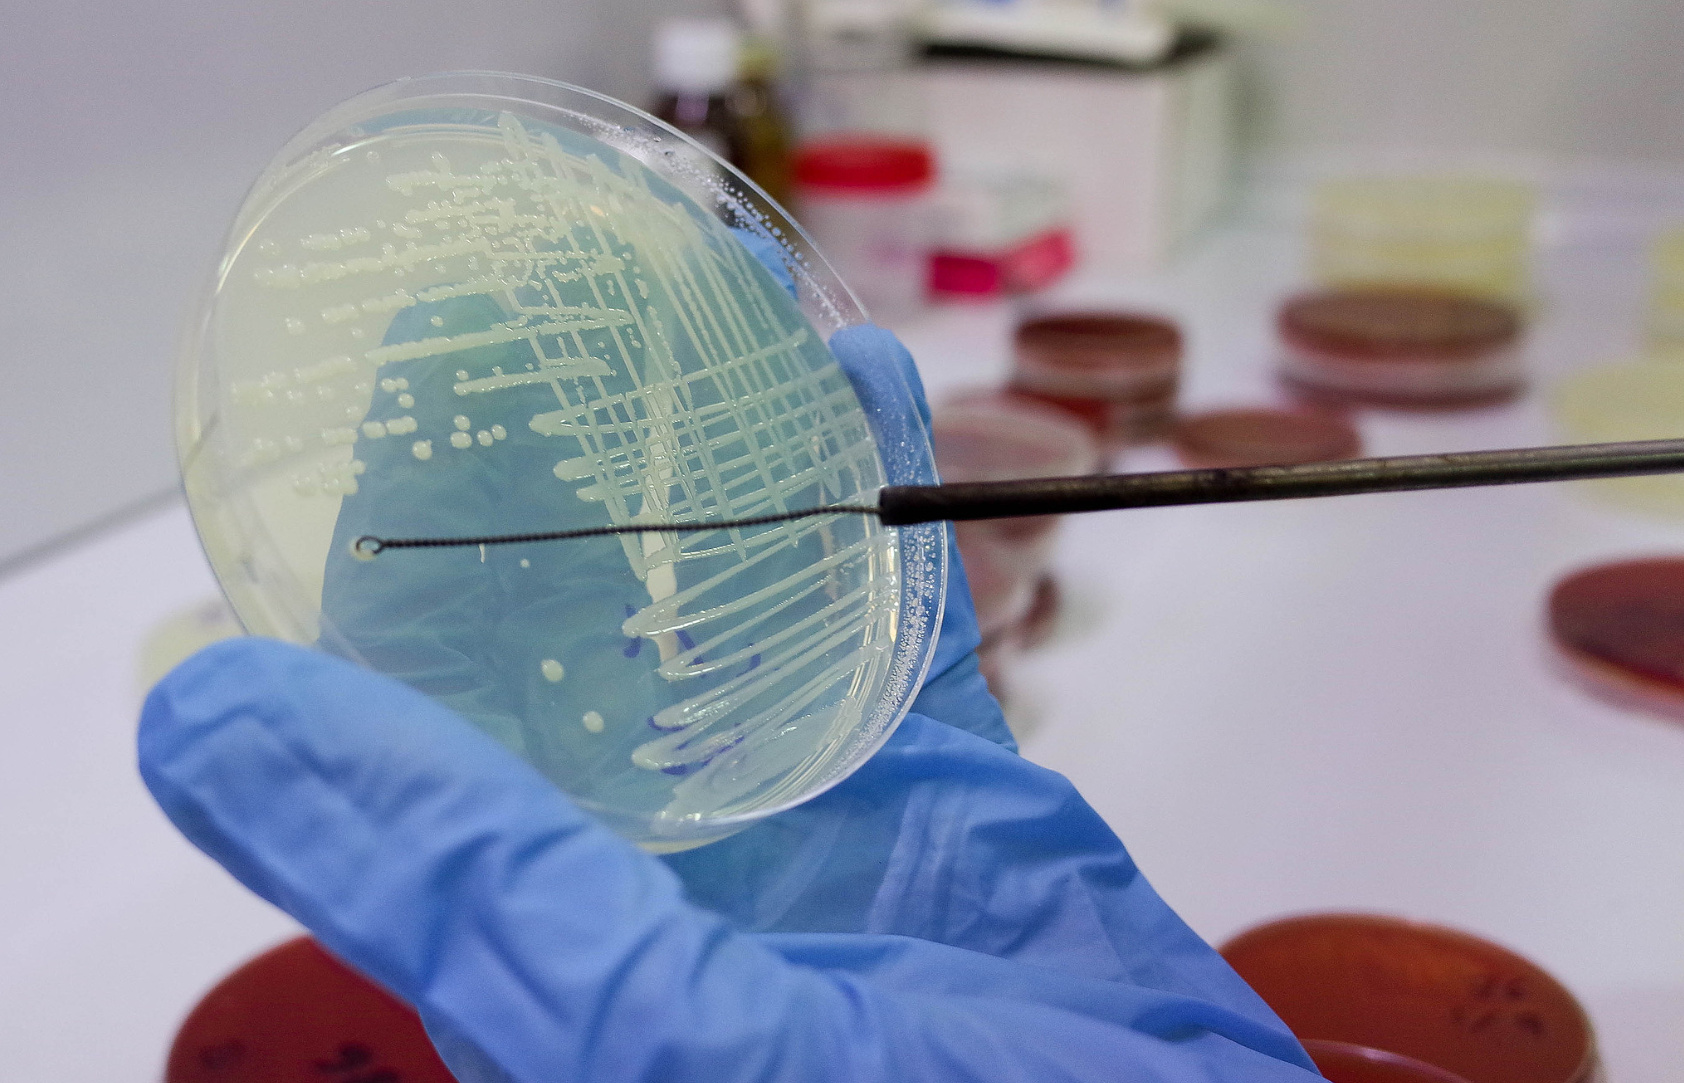

近日,由天益空间生物科技(无锡)有限公司参与编制的《益生菌与药食同源植物成分协同作用评价》团体标准(编号:T/FDSA 0104—2025)已正式获批发布,并于2025年12月18日起全面实施!

该标准汇集了无限极(中国)有限公司、广东正当年生物科技股份有限公司、哈尔滨工业大学、绿之韵生物工程集团有限公司、上海康识食品科技有限公司、中科埃微生物技术有限公司、三株福尔制药有限公司、固正保和中医药科技(成都)有限公司、山东国和堂制药有限公司、海南大学、微康益生菌(苏州)股份有限公司、天益空间生物科技(无锡)有限公司、湖南益百益优生物科技有限公司、上海佑今生健康科技有限公司、山东环亿生物科技有限公司、芜湖鲨鱼菲特健康科技有限公司、郑州金百合生物工程有限公司、上海甘泓生物医学科技有限公司、健码制药(广东)有限公司、华大精准营养(深圳)科技有限公司、浙江大医德美生物科技有限公司、宁夏普世特膳科技有限公司、甘肃集本草健康生物科技有限公司、江苏省中医药研究院、厦门元之道生物科技有限公司、江苏美济制药集团有限公司、天津创源生物技术有限公司、吉林省知遇健康股份有限公司、中国保健协会食物营养与安全委员会等近三十家企业、高校及科研机构的专业力量,共同为《益生菌与药食同源植物成分协同作用评价》团体标准的制定提供坚实的理论基础和创新思路。


该标准规定了益生菌与药食同源植物成分协同作用评价的术语和定义、基本原则、评价指标体系、评价方法、评价流程、结果判定及分级、质量控制与保证、评价报告等,为“益生菌+药食同源”产品提供了科学、统一的评价规范,将有效促进行业健康有序发展。
天益空间生物:为标准提供技术支撑
作为专业从事空间微生物科学研究、开发、孵化及产业化应用的航天科技企业,天益空间生物始终秉持“探索空间生物科技,聚焦地球生命健康”的理念,在标准编制过程中积极建言献策,为标准条款的科学性、实用性提供有力支撑。

公司建有国内领先、规模大、涉及领域广、食药应用价值高的7000余株空间微生物菌种库,涵盖太空功能性食品、保健品、化妆品、乳制品、酒业、生物制药、生物饲料、衍生日用品、太空及地面食品防腐保鲜、环境治理、药物选育途径等多个领域,为益生菌与药食同源植物成分的协同研究提供了丰富的实验样本和数据支持。
未来,天益空间生物将持续以标准为引领,深化益生菌与药食同源植物成分的协同功效在改善肠胃健康、免疫调节作用、其他生理功能调节(降血糖、降血脂、降尿酸、控制体重、护眼、生物防腐保鲜、改善睡眠与情绪等)方面的技术创新与融合应用。

同时,天益空间生物将积极推动标准落地实施,为客户提供更优质的健康解决方案。公司也将继续积极参与更多标准的制定工作,以技术创新赋能标准升级,以标准规范引领产业进步,为我国食品药品企业质量安全发展贡献更多的天益力量!